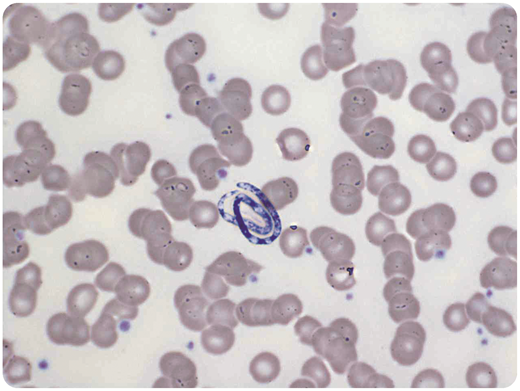
A 48-year-old white Portuguese man with no significant travel history was admitted to our center for stem cell harvesting after stimulation with granulocyte colony-stimulating factor. He was in complete remission of a relapsed aggressive B-cell lymphoma, and autologous stem cell transplantation was planned as salvage therapy. As a standard procedure, the patient was admitted to the hospital the night before the planned stem cell harvest. During routine analysis, the peripheral blood smear showed a 70-μm-long organism, and the presence of microfilariae was suspected (100× objective, May-Grünwald-Giemsa stain). A large serological panel to exclude different forms of parasitosis was initiated. The patient received an empirical single dose of ivermectin. However, the size of the microorganism excluded the possibility that the organism was a species of microfilaria. Microfilariae are usually between 200 and 300 μm in size, at least 3 times as long as the organism on the blood smear. Finally, secondary contamination of the peripheral blood smear with Helicosporium was confirmed, and the stem cell harvest was performed as planned. / Helicosporium is a fungal spore that can rarely contaminate smears of peripheral blood. Awareness of possible contamination of smears with Helicosporium is important to avoid unnecessary treatment or delayed procedures in patients.

A 48-year-old white Portuguese man with no significant travel history was admitted to our center for stem cell harvesting after stimulation with granulocyte colony-stimulating factor. He was in complete remission of a relapsed aggressive B-cell lymphoma, and autologous stem cell transplantation was planned as salvage therapy. As a standard procedure, the patient was admitted to the hospital the night before the planned stem cell harvest. During routine analysis, the peripheral blood smear showed a 70-μm-long organism, and the presence of microfilariae was suspected (100× objective, May-Grünwald-Giemsa stain). A large serological panel to exclude different forms of parasitosis was initiated. The patient received an empirical single dose of ivermectin. However, the size of the microorganism excluded the possibility that the organism was a species of microfilaria. Microfilariae are usually between 200 and 300 μm in size, at least 3 times as long as the organism on the blood smear. Finally, secondary contamination of the peripheral blood smear with Helicosporium was confirmed, and the stem cell harvest was performed as planned.
Helicosporium is a fungal spore that can rarely contaminate smears of peripheral blood. Awareness of possible contamination of smears with Helicosporium is important to avoid unnecessary treatment or delayed procedures in patients.
A 48-year-old white Portuguese man with no significant travel history was admitted to our center for stem cell harvesting after stimulation with granulocyte colony-stimulating factor. He was in complete remission of a relapsed aggressive B-cell lymphoma, and autologous stem cell transplantation was planned as salvage therapy. As a standard procedure, the patient was admitted to the hospital the night before the planned stem cell harvest. During routine analysis, the peripheral blood smear showed a 70-μm-long organism, and the presence of microfilariae was suspected (100× objective, May-Grünwald-Giemsa stain). A large serological panel to exclude different forms of parasitosis was initiated. The patient received an empirical single dose of ivermectin. However, the size of the microorganism excluded the possibility that the organism was a species of microfilaria. Microfilariae are usually between 200 and 300 μm in size, at least 3 times as long as the organism on the blood smear. Finally, secondary contamination of the peripheral blood smear with Helicosporium was confirmed, and the stem cell harvest was performed as planned.
Helicosporium is a fungal spore that can rarely contaminate smears of peripheral blood. Awareness of possible contamination of smears with Helicosporium is important to avoid unnecessary treatment or delayed procedures in patients.
For additional images, visit the ASH Image Bank, a reference and teaching tool that is continually updated with new atlas and case study images. For more information, visit http://imagebank.hematology.org.

This feature is available to Subscribers Only
Sign In or Create an Account Close Modal